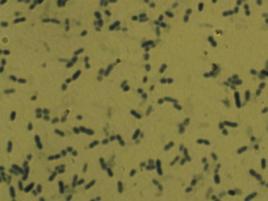
醋杆菌

醋酸菌显微镜

醋酸杆菌显微镜图片
图片尺寸300x222醋酸菌
图片尺寸1200x857
醋酸菌图册_百度百科
图片尺寸500x392醋酸菌
图片尺寸1200x857
醋酸菌.jpg
图片尺寸450x295醋酸菌
图片尺寸1200x857
乳酸菌醋酸菌了解一下
图片尺寸1080x809醋杆菌
图片尺寸268x201
显微镜下的世界
图片尺寸1200x953
显微镜下制造纤维的木质醋酸菌 | 图源:hirai et al. 2002
图片尺寸550x269
醋酸杆菌
图片尺寸220x165
葡萄醋氧化醋酸菌及其应用的制作方法
图片尺寸1000x582
醋酸杆菌
图片尺寸220x160
(2)醋酸菌在大曲中以杆菌居多,属好气菌.
图片尺寸500x375
细菌|红茶菌|微生物|纤维素|醋酸菌_网易订阅
图片尺寸640x564
乳酸菌是细菌还是真菌 醋酸菌是真菌还是细菌
图片尺寸500x375揭开未知菌种的神秘面纱
图片尺寸500x497
醋酸菌醋酸菌鉴定拜托大家了
图片尺寸750x750
直到1837年,醋酸菌这种微生物第一次在显微镜下被观察到.
图片尺寸891x1336
制作果醋——醋酸菌 酵母菌——真菌 醋酸菌——细菌
图片尺寸1080x810